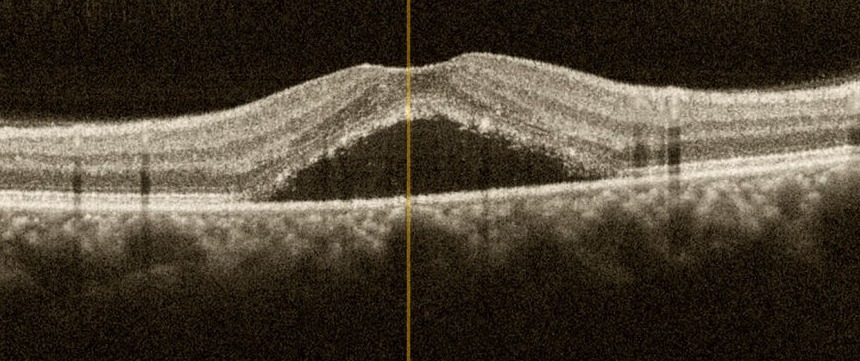
Mobirise

SSR'de OKT görüntüsü
Santral Seröz Retinopati (SSR)
Santral seröz retinopati (SSR) retina altında sıvı birikmesine neden olan bir bozukluktur. Sıvı retinanın dışında yer alan damar tabakadan yani “koroid” dokusundan sızıntı şeklinde yayılarak retinanın altında toplanır ve bu nedenle “santral seröz koryoretinopati” olarak da adlandırılır. Aniden ve ağrısız görme kaybıyla başlayan bu durum erkeklerde daha fazla görülür ve sıklıkla kendiliğinden iyileşir. Ancak tekrar edebilir, hatta bazen kronik hale gelir ve bu durum kalıcı görme kaybıyla sonuçlanabilir.
Sıklıkla tek gözde tespit edilmekle birlikte, dikkatli bir muayene ile diğer gözde de tutulum olduğu anlaşılabilir. Sıvının retinada biriktiği yerin makulaya yani sarı noktaya olan uzaklığına ve sıvının miktarına göre değişen şiddetlerde görme azalır.
Nedeni tam olarak bilinmemekle birlikte özellikle kan kortizol seviyesinin yükseldiği stresli kişilerde ve steroid tedavisi uygulananlarda daha fazla görüldüğü bilinmektedir.
Tanıda rutin göz muayenesine ilave olarak “optik koherens tomografi” yeterli olmakla birlikte, “flöresein anjiyografi” sızıntının yerinin tespitinde ve olası diğer retina hastalıklarının ayırıcı tanısında yararlıdır.
Santral seröz retinopati tespit edilen hastaların çoğu birkaç ay içinde kendiliğinden iyileştiği için sadece “takip etmek” yeterli olmaktadır. “Soğuk lazer” olarak da bilinen “fotodinamik tedavi” kendiliğinden düzelmenin olmadığı durumlarda sızıntının durdurulmasında oldukça etkili bir seçenek olarak gözükmektedir. Diğer bir tedavi seçeneği “mikropulse” lazer yöntemidir. Bu yöntemle sızıntı bölgesine düşük enerjili lazer uygulanarak retina altında toplanan sıvının emilimi sağlanır, ancak fotodinamik tedavi kadar etkili olmadığı düşünülmektedir.
